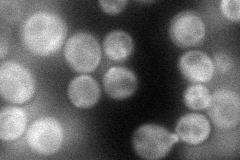
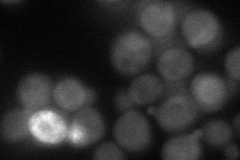
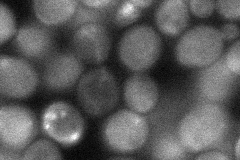
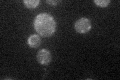

View description
Protein that acts as an adaptor between Myo4p and the She2p-mRNA complex; part of the mRNA localization machinery that restricts accumulation of certain proteins to the bud; also required for cortical ER inheritance
Localization:
Intensity:
Fold change:
Significance:
-
C’ GFP library in SD

bud neck37.4 -
N' NOP1pr-GFP in SD
cytosol,bud70.0959 -
N' TEF2pr-mCherry in SD
bud64.1517 -
N' NATIVEpr-GFP in SD

bud37.1255 -
N' TEF2pr-VC and Cyto-VN in SD
cytosol39.617 -
C’ GFP library in SD+DTT

bud neck37.61No -
C’ GFP library in SD+H2O2

cytosol44.51.18No -
C’ GFP library in Starvation Media
punctateN/AN/AYes -
C’ GFP library on the background of Pup2-DaMP

cytosol -
C’ GFP library on the background of CCT mutant

cytosol50.161.34094No
